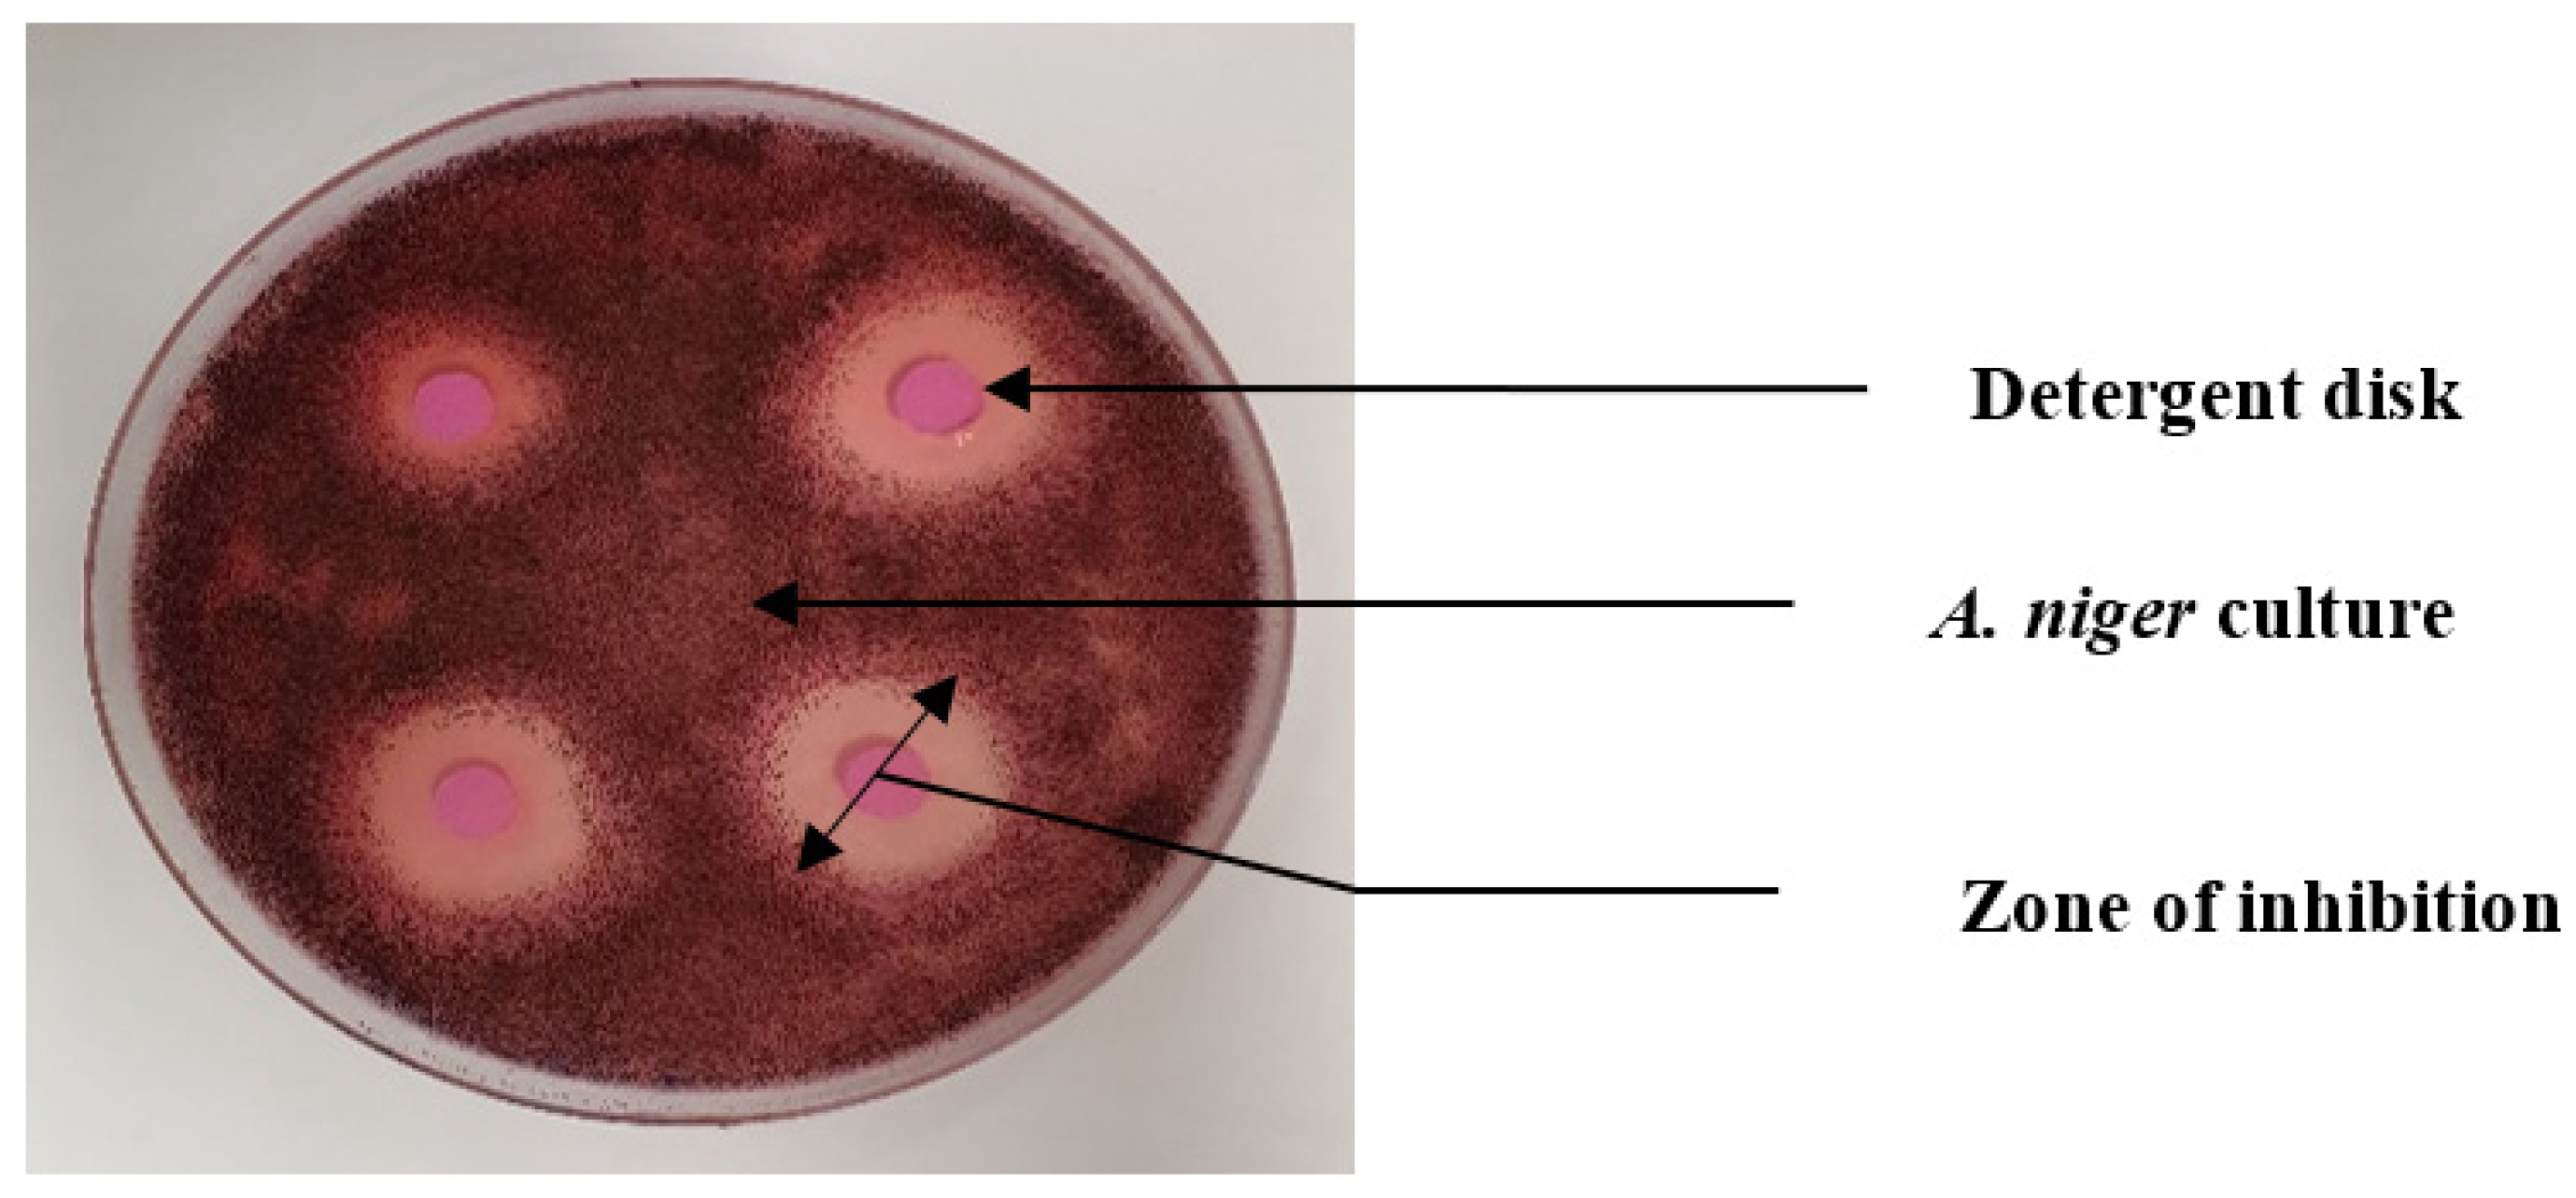

Impact of the Aging Process on the Ability of Decorative Materials Containing Biocides to Support Fungal Growth
Abstract
1. Introduction
2. Materials and Methods
2.1. Building and Decorative Materials
- -
- Polyester Cellulose (PEC): Smooth renovation wall covering containing polyester and cellulose. It is used in this study as a support for decorative materials and as a positive control for fungal growth.
- -
- Antifungal paint (AFP): Suitable for all interior surfaces thanks to its moisture resistance and mold prevention. It contains acrylic resin, titanium pigment, and iron oxide. Biocides include 2,4,7,9-tetramethyldec-5-yne-4,7-diol (TMetdediol), 3-iodo-2-propynyl butylcarbamate (IPBC), and 1,2-benzisothiazol-3(2H)-one (BIT), whose concentrations are not provided by the manufacturer.
- -
- Normal Acrylic paint (AP): Suitable for damp surfaces. It is resistant to water and temperature variations. It contains the following biocides: 5-chloro-2-methyl-4-isothiazolin-3-one and 2-methyl-2H-isothiazol-3-one (3:1) (CMIT/MIT) as well as 1,2-benzothiazol-3(2H)-one (BIT), which are labeled as preservatives for liquid paint storage.
2.2. Methodology
- -
- Six samples (3 native and 3 aged) were used for biocide Emission Rate (ER) measurements to examine the differences in emissions between native and aged samples.
- -
- Twelve samples were subjected to fungal inoculation by dry aerosolization and divided as follows: six samples (3 native and 3 aged) were tested for biocide ER. These measurements are intended to assess the effects of high-humidity incubation and possible fungal growth on the material. The remaining six inoculated samples (3 native and 3 aged) were subjected to quantitative measurements of fungal concentration, expressed in CFU cm−2.
2.2.1. Sample Preparation
- -
- Twelve (3 native, 3 aged, and 6 inoculated incubated native and aged) samples were used to evaluate the biocide ER;
- -
- Twelve (3 native and 9 aged) samples were used to evaluate the ability of the material to promote fungal growth after 30 days of incubation under high relative humidity (95 ± 5%);
- -
- Eighteen samples were designated to monitor the growth/survival of deposited spores on the native materials during the 30 days of incubation by evaluating the fungal growth on 3 samples out of the 18 every 7 days. The significant difference between the concentration of initially inoculated spores on the first day (D0) and those on the other sampling days was calculated using a nonparametric Kruskal–Wallis test with an alpha risk of 0.05%, followed by Dunn’s correction;
- -
- Six (3 native and 3 aged) samples on which 8 mL of a nutrient solution (10 g L−1 Tryptone—5 g L−1 Meat extract—5 g L−1 Sodium chloride) was added to evaluate the depletion of biocides over time (before and after the aging process).
2.2.2. Material Aging
- (1)
- “Cleaning Product and Light Aging Process” (CPLAP): This involved adding a commercial cleaning product, with the aim of reproducing real-life conditions and daily cleaning habits. The composition of the cleaning product, used during the aging process, was determined by spiking 1 µL of this product into a Tenax TA adsorbent tube and then analyzing it by TD-GC-MS/FID. During the aging process, 869 ± 61 µL of this detergent was sprayed twice a day for one month onto the aging samples. After a 5 min application, the detergent was wiped off with a paper towel to simulate typical occupant cleaning habits and accelerate the aging process. The material was also continuously exposed to a visible light spectrum (400–450 nm to 600–650 nm) for 30 days. The distance between the light and the samples was equal to 48 cm (Figure 2).
- (2)
- “Water and Light Aging Process” (WLAP): This test is similar to the previous one, except 803 ± 132 µL of ultra-pure water, instead of the cleaning product, was sprayed twice a day for one month on the surface of the material.
- (3)
- “Light Aging Process” (LAP): This consisted only of continuous exposure of the samples to the visible light spectrum for 30 days.
2.2.3. Fungal Inoculation
2.2.4. Fungal Growth Assessment
2.2.5. Variation in Biocide Emission Rates from Acrylic Paints After Aging and Incubation Process
2.2.6. Paint Characterization
3. Results and Discussion
3.1. Material Characterizations
3.2. Biodegradability of Decorative Materials Under Different Aging Conditions
3.2.1. Antifungal Paint (AFP)
3.2.2. Acrylic Paint (AP)
3.3. Variation in Biocide Emission Rates from Antifungal Paints After Aging and Incubation Process
3.4. Assessment of the Effectiveness of Biocides in Decorative Materials
4. Conclusions
- Stage 1: Paint characterization
- Stage 2: Biodegradability of two acrylic paints under different aging conditions
- Antifungal acrylic paint, in its native or aged state, protects the polyester cellulose wall covering against fungal growth, thanks to its biocide content. In contrast, normal acrylic paint, which contains biocides mainly to preserve it in a liquid state, promotes fungal growth.
- The aging process with a cleaning agent offers additional protection of the material against fungal growth due to its antifungal ingredients. On the other hand, the aging process with water leads to the deterioration of the material and favors a higher fungal growth compared to the native material.
- Stage 3: Biocide depletion during aging
- Stage 4: Assessment of the effectiveness of biocides
Author Contributions
Funding
Data Availability Statement
Conflicts of Interest
References
- Habre, R.; Coull, B.; Moshier, E.; Godbold, J.; Grunin, A.; Nath, A.; Castro, W.; Schachter, N.; Rohr, A.; Kattan, M.; et al. Sources of indoor air pollution in New York City residences of asthmatic children. J. Expo. Sci. Environ. Epidemiol. 2014, 24, 269–278. [Google Scholar] [CrossRef] [PubMed]
- Yuan, Y.; Luo, Z.; Liu, J.; Wang, Y.; Lin, Y. Health and economic benefits of building ventilation interventions for reducing indoor PM2.5 exposure from both indoor and outdoor origins in urban Beijing, China. Sci. Total Environ. 2018, 626, 546–554. [Google Scholar] [CrossRef] [PubMed]
- Lueker, J.; Bardhan, R.; Sarkar, A.; Norford, L. Indoor air quality among Mumbai’s resettled populations: Comparing Dharavi slum to nearby rehabilitation sites. Build. Environ. 2020, 167, 106419. [Google Scholar] [CrossRef]
- Awada, M.; Becerik-Gerber, B.; Hoque, S.; O’Neill, Z.; Pedrielli, G.; Wen, J.; Wu, T. Ten questions concerning occupant health in buildings during normal operations and extreme events including the COVID-19 pandemic. Build. Environ. 2020, 188, 107480. [Google Scholar] [CrossRef] [PubMed]
- ANSES. Moisissures Dans le Bâti. Avis de l’Anses Rapport D’expertise Collective. 2016. Available online: https://www.anses.fr/en/system/files/AIR2014SA0016Ra.pdf (accessed on 25 November 2024).
- Verdier, T.; Coutand, M.; Bertron, A.; Roques, C. A review of indoor microbial growth across building materials and sampling and analysis methods. Build. Environ. 2014, 80, 136–149. [Google Scholar] [CrossRef]
- Abe, K. Assessment of the environmental conditions in a museum storehouse by use of a fungal index. Int. Biodeterior. Biodegrad. 2010, 64, 32–40. [Google Scholar] [CrossRef]
- ADEME. Guide-Un Air Sain Chez Soi. 2017. Available online: https://www.ademe.fr/sites/default/files/assets/documents/guide-pratique-un-air-sain-chez-soi.pdf (accessed on 7 October 2021).
- Viel, M.; Collet, F.; Lecieux, Y.; François, M.L.M.; Colson, V.; Lanos, C.; Hussain, A.; Lawrence, M. Resistance to mold development assessment of bio-based building materials. Compos. Part. B Eng. 2019, 158, 406–418. [Google Scholar] [CrossRef]
- Dean, T.; Betancourt, D. Microbial Resistant Test Method Development; EPA: Washington, DC, USA, 2014; p. 49. [Google Scholar]
- Lacaze, I.; Moularat, S.; Bousta, F.; Draghi, M.; Silar, P.; Robine, E. Étude de la dynamique de colonisation microbienne de produits de construction. Matériaux Tech. 2016, 104, 507. [Google Scholar] [CrossRef]
- Deacon, J. Fungal Biology, 4th ed.; Wiley–Blackwell: Malden, MA, USA, 2005; ISBN 978-1-4051-3066-0. [Google Scholar]
- Johansson, P.; Ekstrand-Tobin, A.; Svensson, T.; Bok, G. Laboratory study to determine the critical moisture level for mould growth on building materials. Int. Biodeterior. Biodegrad. 2012, 73, 23–32. [Google Scholar] [CrossRef]
- Vacher, S.; Hernandez, C.; Bärtschi, C.; Poussereau, N. Impact of paint and wall-paper on mould growth on plasterboards and aluminum. Build. Environ. 2010, 45, 916–921. [Google Scholar] [CrossRef]
- Laycock, B.; Nikolić, M.; Colwell, J.M.; Gauthier, E.; Halley, P.; Bottle, S.; George, G. Lifetime prediction of biodegradable polymers. Prog. Polym. Sci. 2017, 71, 144–189. [Google Scholar] [CrossRef]
- Singh, B.; Sharma, N. Mechanistic implications of plastic degradation. Polym. Degrad. Stab. 2008, 93, 561–584. [Google Scholar] [CrossRef]
- Zervos, S. Natural and accelerated ageing of cellulose and paper: A literature review. In Cellulose: Structure and Properties, Derivatives and Industrial Uses; Nova Publishing: New York, NY, USA, 2010; pp. 155–203. [Google Scholar]
- Garg, K.L.; Jain, K.K.; Mishra, A.K. Role of fungi in the deterioration of wall paintings. Sci. Total Environ. 1995, 167, 255–271. [Google Scholar] [CrossRef]
- Agrawal, O.P.; Dhawan, S.; Garg, K.L.; Shaheen, F.; Pathak, N.; Misra, A. Study of biodeterioration of the Ajanta wall paintings. Int. Biodeterior. 1988, 24, 121–129. [Google Scholar] [CrossRef]
- Korpi, A.; Järnberg, J.; Pasanen, A.-L. Microbial Volatile Organic Compounds. Crit. Rev. Toxicol. 2009, 39, 139–193. [Google Scholar] [CrossRef] [PubMed]
- Aleksic, B.; Draghi, M.; Ritoux, S.; Bailly, S.; Lacroix, M.; Oswald, I.P.; Bailly, J.-D.; Robine, E. Aerosolization of Mycotoxins after Growth of Toxinogenic Fungi on Wallpaper. Appl. Environ. Microbiol. 2017, 83, e01001-17. [Google Scholar] [CrossRef]
- World Health Organization. WHO Guidelines for Indoor Air Quality: Dampness and Mould; WHO: Copenhagen, Denmark, 2009; ISBN 978-92-890-4168-3. [Google Scholar]
- Casas, L.; Dumas, O.; Le Moual, N. Chapter 6-Indoor Air and Respiratory Health: Volatile Organic Compounds and Cleaning Products. In Asthma in the 21st Century; Nadif, R., Ed.; Academic Press: Cambridge, MA, USA, 2023; pp. 135–150. ISBN 978-0-323-85419-1. [Google Scholar]
- Dewey, H.M.; Jones, J.M.; Keating, M.R.; Budhathoki-Uprety, J. Increased Use of Disinfectants during the COVID-19 Pandemic and Its Potential Impacts on Health and Safety. ACS Chem. Health Saf. 2022, 29, 27–38. [Google Scholar] [CrossRef]
- Hora, P.I.; Pati, S.G.; McNamara, P.J.; Arnold, W.A. Increased Use of Quaternary Ammonium Compounds during the SARS-CoV-2 Pandemic and Beyond: Consideration of Environmental Implications. Environ. Sci. Technol. Lett. 2020, 7, 622–631. [Google Scholar] [CrossRef]
- Lou, J.; Wang, W.; Lu, H.; Wang, L.; Zhu, L. Increased disinfection byproducts in the air resulting from intensified disinfection during the COVID-19 pandemic. J. Hazard. Mater. 2021, 418, 126249. [Google Scholar] [CrossRef]
- Koksoy Vayisoglu, S.; Oncu, E. The use of cleaning products and its relationship with the increasing health risks during the COVID-19 pandemic. Int. J. Clin. Pract. 2021, 75, e14534. [Google Scholar] [CrossRef]
- Gharpure, R. Knowledge and Practices Regarding Safe Household Cleaning and Disinfection for COVID-19 Prevention—United States, May 2020. Morb. Mortal. Wkly. Rep. 2020, 69, 705–709. [Google Scholar] [CrossRef] [PubMed]
- Le Roux, G.; Sinno-Tellier, S.; Puskarczyk, E.; Labadie, M.; von Fabeck, K.; Pélissier, F.; Nisse, P.; Paret, N.; Descatha, A.; Vodovar, D. Poisoning during the COVID-19 outbreak and lockdown: Retrospective analysis of exposures reported to French poison control centres. Clin. Toxicol. 2021, 59, 832–839. [Google Scholar] [CrossRef] [PubMed]
- Nicole, W. Youth in Action: Local Teens Help Assess Chemical Exposures from Household Cleaning Products. Environ. Health Perspect. 2021, 129, 104002. [Google Scholar] [CrossRef] [PubMed]
- Salonen, H.; Salthammer, T.; Morawska, L. Human exposure to ozone in school and office indoor environments. Environ. Int. 2018, 119, 503–514. [Google Scholar] [CrossRef]
- Wei, W.; Boumier, J.; Wyart, G.; Ramalho, O.; Mandin, C. Cleaning practices and cleaning products in nurseries and schools: To what extent can they impact indoor air quality? Indoor Air 2016, 26, 517–525. [Google Scholar] [CrossRef] [PubMed]
- Wolkoff, P.; Schneider, T.; Kildesø, J.; Degerth, R.; Jaroszewski, M.; Schunk, H. Risk in cleaning: Chemical and physical exposure. Sci. Total Environ. 1998, 215, 135–156. [Google Scholar] [CrossRef] [PubMed]
- Weschler, C.J. Changes in indoor pollutants since the 1950s. Atmos. Environ. 2009, 43, 153–169. [Google Scholar] [CrossRef]
- Uhde, E.; Salthammer, T. Impact of reaction products from building materials and furnishings on indoor air quality—A review of recent advances in indoor chemistry. Atmos. Environ. 2007, 41, 3111–3128. [Google Scholar] [CrossRef]
- Ormsby, B. An FTIR-based Exploration of the Effects of Wet Cleaning Treatments on Artists’ Acrylic Emulsion Paint Films. E-Preserv. Sci. 2009, 6, 186–195. [Google Scholar]
- Dillon, C.E.; Lagalante, A.F.; Wolbers, R.C. Acrylic emulsion paint films: The effect of solution pH, conductivity, and ionic strength on film swelling and surfactant removal. Stud. Conserv. 2014, 59, 52–62. [Google Scholar] [CrossRef]
- European Union. European Parliament and Council Regulation (EU) No 528/2012 concerning the making available on the market and use of biocidal products. Off. J. Eur. Union. 2012, L167, 1–123. [Google Scholar]
- European Union. European Parliament and Council Regulation (EC) No 1223/2009 on cosmetic products. Off. J. Eur. Union 2009, L342, 29–209. [Google Scholar]
- Paulus, W. Directory of Microbicides for the Protection of Materials: A Handbook; Springer Science & Business Media: Berlin/Heidelberg, Germany, 2005; ISBN 978-1-4020-2817-5. [Google Scholar]
- Styszko, K.; Bollmann, U.E.; Wangler, T.P.; Bester, K. Desorption of biocides from renders modified with acrylate and silicone. Chemosphere 2014, 95, 188–192. [Google Scholar] [CrossRef] [PubMed]
- Silva, V.; Silva, C.; Soares, P.; Garrido, E.M.; Borges, F.; Garrido, J. Isothiazolinone Biocides: Chemistry, Biological, and Toxicity Profiles. Molecules 2020, 25, 991. [Google Scholar] [CrossRef]
- Lundov, M.D.; Kolarik, B.; Bossi, R.; Gunnarsen, L.; Johansen, J.D. Emission of Isothiazolinones from Water-Based Paints. Environ. Sci. Technol. 2014, 48, 6989–6994. [Google Scholar] [CrossRef] [PubMed]
- Bollmann, U.E.; Vollertsen, J.; Carmeliet, J.; Bester, K. Dynamics of biocide emissions from buildings in a suburban stormwater catchment—Concentrations, mass loads and emission processes. Water Res. 2014, 56, 66–76. [Google Scholar] [CrossRef]
- Bollmann, U.E.; Minelgaite, G.; Schlüsener, M.; Ternes, T.A.; Vollertsen, J.; Bester, K. Photodegradation of octylisothiazolinone and semi-field emissions from facade coatings. Sci. Rep. 2017, 7, 41501. [Google Scholar] [CrossRef]
- Mardones, L.E.; Legnoverde, M.S.; Pereyra, A.M.; Basaldella, E.I. Long-lasting isothiazolinone-based biocide obtained by encapsulation in micron-sized mesoporous matrices. Prog. Org. Coat. 2018, 119, 155–163. [Google Scholar] [CrossRef]
- Burkhardt, M.; Zuleeg, S.; Vonbank, R.; Bester, K.; Carmeliet, J.; Boller, M.; Wangler, T. Leaching of Biocides from Façades under Natural Weather Conditions. Environ. Sci. Technol. 2012, 46, 5497–5503. [Google Scholar] [CrossRef] [PubMed]
- Styszko, K.; Bollmann, U.E.; Bester, K. Leaching of biocides from polymer renders under wet/dry cycles—Rates and mechanisms. Chemosphere 2015, 138, 609–615. [Google Scholar] [CrossRef]
- Burkhardt, M.; Zuleeg, S.; Vonbank, R.; Schmid, P.; Hean, S.; Lamani, X.; Bester, K.; Boller, M. Leaching of additives from construction materials to urban storm water runoff. Water Sci. Technol. 2011, 63, 1974–1982. [Google Scholar] [CrossRef] [PubMed]
- Bollmann, U.E.; Minelgaite, G.; Schlüsener, M.; Ternes, T.; Vollertsen, J.; Bester, K. Leaching of Terbutryn and Its Photodegradation Products from Artificial Walls under Natural Weather Conditions. Environ. Sci. Technol. 2016, 50, 4289–4295. [Google Scholar] [CrossRef] [PubMed]
- Wang, T.; Wu, Q.-Y.; Wang, W.-L.; Chen, Z.; Li, B.-T.; Li, A.; Liu, Z.-Y.; Hu, H.-Y. Self-sensitized photodegradation of benzisothiazolinone by low-pressure UV-C irradiation: Kinetics, mechanisms, and the effect of media. Sep. Purif. Technol. 2017, 189, 419–424. [Google Scholar] [CrossRef]
- Chen, L.; Xu, Y.; Wang, W.; Qian, P.-Y. Degradation kinetics of a potent antifouling agent, butenolide, under various environmental conditions. Chemosphere 2015, 119, 1075–1083. [Google Scholar] [CrossRef] [PubMed]
- Park, S.-K.; Kwon, J.-H. The fate of two isothiazolinone biocides, 5-chloro-2-methylisothiazol-3(2H)-one (CMI) and 2-methylisothiazol-3(2H)-one (MI), in liquid air fresheners and assessment of inhalation exposure. Chemosphere 2016, 144, 2270–2276. [Google Scholar] [CrossRef] [PubMed]
- Krzeminski, S.F.; Brackett, C.K.; Fisher, J.D.; Spinnler, J.F. Fate of microbicidal 3-isothiazolone compounds in the environment. Products of degradation. J. Agric. Food Chem. 1975, 23, 1068–1075. [Google Scholar] [CrossRef] [PubMed]
- Ciferri, O. Microbial Degradation of Paintings. Appl. Environ. Microbiol. 1999, 65, 879–885. [Google Scholar] [CrossRef] [PubMed]
- Reis-Menezes, A.A.; Gambale, W.; Giudice, M.C.; Shirakawa, M.A. Accelerated testing of mold growth on traditional and recycled book paper. Int. Biodeterior. Biodegrad. 2011, 65, 423–428. [Google Scholar] [CrossRef]
- Segers, F.J.J.; van Laarhoven, K.A.; Huinink, H.P.; Adan, O.C.G.; Wösten, H.A.B.; Dijksterhuis, J. The Indoor Fungus Cladosporium halotolerans Survives Humidity Dynamics Markedly Better than Aspergillus niger and Penicillium rubens despite Less Growth at Lowered Steady-State Water Activity. Appl. Environ. Microbiol. 2016, 82, 5089–5098. [Google Scholar] [CrossRef]
- Tobon, A.M.; Andres, Y.; Locoge, N. Impacts of test methods on the assessment of insulation materials’ resistance against moulds. Build. Environ. 2020, 179, 106963. [Google Scholar] [CrossRef]
- Zine-Filali, N.; Braish, T.; Locoge, N.; Andres, Y. Effect of Aging on Decorative and Renovation Products Containing Biocides: Assessment of Its Impact on Indoor Air Quality; SINTEF Academic Press: Trondheim, Norway, 2021; ISBN 978-82-536-1728-2. Available online: https://sintef.brage.unit.no/sintef-xmlui/handle/11250/2839152 (accessed on 4 May 2022).
- ISO 16000-6; Indoor Air—Part 6: Determination of Organic Compounds (VVOC, VOC, SVOC) in Indoor and Test Chamber Air by Active Sampling on Sorbent Tubes, Thermal Desorption and Gas Chromatography Using MS or MS FID. ISO: Geneva, Switzerland, 2021. Available online: https://www.iso.org/standard/73522.html (accessed on 25 November 2024).
- Zine Filali, N.; Braish, T.; Andres, Y.; Locoge, N. Measurement reproducibility and storage impact on VOC/SVOC emission rate from decorative materials. Chemosphere 2024, 367, 143607. [Google Scholar] [CrossRef] [PubMed]
- Pinzari, F.; Pasquariello, G.; De Mico, A. Biodeterioration of Paper: A SEM Study of Fungal Spoilage Reproduced Under Controlled Conditions. Macromol. Symp. 2006, 238, 57–66. [Google Scholar] [CrossRef]
- Jerusik, R.J. Fungi and paper manufacture. Fungal Biol. Rev. 2010, 24, 68–72. [Google Scholar] [CrossRef]
- Lin, C.-C.; Chen, W.-Y. Effect of paint composition, nano-metal types and substrate on the improvement of biological resistance on paint finished building material. Build. Environ. 2017, 117, 49–59. [Google Scholar] [CrossRef]
- Lamarre, C.; Sokol, S.; Debeaupuis, J.-P.; Henry, C.; Lacroix, C.; Glaser, P.; Coppée, J.-Y.; François, J.-M.; Latgé, J.-P. Transcriptomic analysis of the exit from dormancy of Aspergillus fumigatus conidia. BMC Genom. 2008, 9, 417. [Google Scholar] [CrossRef] [PubMed]
- Van Leeuwen, M.R.; Krijgsheld, P.; Bleichrodt, R.; Menke, H.; Stam, H.; Stark, J.; Wösten, H.A.B.; Dijksterhuis, J. Germination of conidia of Aspergillus niger is accompanied by major changes in RNA profiles. Stud. Mycol. 2013, 74, 59–70. [Google Scholar] [CrossRef]
- Mercier, B.; Prost, J.; Prost, M. The essential oil of turpentine and its major volatile fraction (α- and β-pinenes): A review. Int. J. Occup. Med. Environ. Health 2009, 22, 331–342. [Google Scholar] [CrossRef]
- Andrews, R.E.; Parks, L.W.; Spence, K.D. Some Effects of Douglas Fir Terpenes on Certain Microorganisms. Appl. Environ. Microbiol. 1980, 40, 301–304. [Google Scholar] [CrossRef]
- Alma, M.H.; Nitz, S.; Kollmannsberger, H.; Digrak, M.; Efe, F.T.; Yilmaz, N. Chemical Composition and Antimicrobial Activity of the Essential Oils from the Gum of Turkish Pistachio (Pistacia vera L.). J. Agric. Food Chem. 2004, 52, 3911–3914. [Google Scholar] [CrossRef]
- Gupta, A.; Jeyakumar, E.; Lawrence, R. Journey of Limonene as an Antimicrobial Agent. J. Pure Appl. Microbiol. 2021, 15, 1094–1110. [Google Scholar] [CrossRef]
- Magwa, M.L.; Gundidza, M.; Gweru, N.; Humphrey, G. Chemical composition and biological activities of essential oil from the leaves of Sesuvium portulacastrum. J. Ethnopharmacol. 2006, 103, 85–89. [Google Scholar] [CrossRef] [PubMed]
- Krauze-Baranowska, M.; Mardarowicz, M.; Wiwart, M.; Pobłocka, L.; Dynowska, M. Antifungal Activity of the Essential Oils from Some Species of the Genus Pinus. Z. Naturforsch. C. 2002, 57, 478–482. [Google Scholar] [CrossRef] [PubMed]
- Singer, H.; Jaus, S.; Hanke, I.; Lück, A.; Hollender, J.; Alder, A.C. Determination of biocides and pesticides by on-line solid phase extraction coupled with mass spectrometry and their behaviour in wastewater and surface water. Environ. Pollut. 2010, 158, 3054–3064. [Google Scholar] [CrossRef] [PubMed]
- Bollmann, U.E.; Tang, C.; Eriksson, E.; Jönsson, K.; Vollertsen, J.; Bester, K. Biocides in urban wastewater treatment plant influent at dry and wet weather: Concentrations, mass flows and possible sources. Water Res. 2014, 60, 64–74. [Google Scholar] [CrossRef] [PubMed]
- Harb, P.; Locoge, N.; Thevenet, F. Emissions and treatment of VOCs emitted from wood-based construction materials: Impact on indoor air quality. Chem. Eng. J. 2018, 354, 641–652. [Google Scholar] [CrossRef]
- Wolkoff, P. Volatile Organic Compounds Sources, Measurements, Emissions, and the Impact on Indoor Air Quality. Indoor Air 1995, 5, 5–73. [Google Scholar] [CrossRef]
- Wolkoff, P. Impact of air velocity, temperature, humidity, and air on long-term voc emissions from building products. Atmos. Environ. 1998, 32, 2659–2668. [Google Scholar] [CrossRef]
- Frenzel, E.; Schmidt, S.; Niederweis, M.; Steinhauer, K. Importance of Porins for Biocide Efficacy against Mycobacterium smegmatis. Appl. Environ. Microbiol. 2011, 77, 3068–3073. [Google Scholar] [CrossRef]
- ANSES. Méthylisothiazolinone Dans les Produits à Usage Courant et Risques Associés de Sensibilisation Cutanée et Respiratoire. Avis de l’Anses Rapport D’expertise Collective. 2016. Available online: https://www.anses.fr/fr/system/files/CONSO2014SA0186Ra.pdf (accessed on 25 November 2024).
- Melo, M.J.; Bracci, S.; Camaiti, M.; Chiantore, O.; Piacenti, F. Photodegradation of acrylic resins used in the conservation of stone. Polym. Degrad. Stab. 1999, 66, 23–30. [Google Scholar] [CrossRef]
- Chiantore, O.; Trossarelli, L.; Lazzari, M. Photooxidative degradation of acrylic and methacrylic polymers. Polymer 2000, 41, 1657–1668. [Google Scholar] [CrossRef]
- Chiantore, O.; Lazzari, M. Photo-oxidative stability of paraloid acrylic protective polymers. Polymer 2001, 42, 17–27. [Google Scholar] [CrossRef]
- McGaugh, M.C.; Kottle, S. The thermal degradation of poly(acrylic acid). J. Polym. Sci. Part. B Polym. Lett. 1967, 5, 817–820. [Google Scholar] [CrossRef]
- Liang, W.; Lv, M.; Yang, X. The combined effects of temperature and humidity on initial emittable formaldehyde concentration of a medium-density fiberboard. Build. Environ. 2016, 98, 80–88. [Google Scholar] [CrossRef]
- Digney-Peer, S.; Bumstock, A.; Leamer, T.; Khanjian, H.; Hoogland, F.; Boon, J. The migration of surfactants in acrylic emulsion paint films. Stud. Conserv. 2014, 49, 202–207. [Google Scholar] [CrossRef]
- Niu, B.-J.; Urban, M.W. Recent advances in stratification and film formation of latex films; attenuated total reflection and step-scan photoacoustic FTIR spectroscopic studies. J. Appl. Polym. Sci. 1998, 70, 1321–1348. [Google Scholar] [CrossRef]
- Kampasakali, E.; Ormsby, B.; Cosentino, A.; Miliani, C.; Learner, T. A Preliminary Evaluation of the Surfaces of Acrylic Emulsion Paint Films and the Effects of Wet-Cleaning Treatment by Atomic Force Microscopy (AFM). Stud. Conserv. 2011, 56, 216–230. [Google Scholar] [CrossRef]
- O’Neill, T.B. Succession and interrelationships of microorganisms on painted surfaces. Int. Biodeterior. 1988, 24, 373–379. [Google Scholar] [CrossRef]

| Compounds/Materials | Polyester-Cellulose | Acrylic Paint | Antifungal Paint |
|---|---|---|---|
| N (wt.%) 1 | <LOQ 2 | 0.6 ± 0.01 | 0.4 ± 0.09 |
| C (wt.%) | 45 ± 0.06 | 35 ± 0.05 | 31 ± 0.002 |
| H (wt.%) | 5 ± 0.05 | 5 ± 0.02 | 4 ± 0.04 |
| S (wt.%) | <LOD | <LOD 3 | <LOD |
| O (wt.%) (by the difference) | 40 ±0.3 | 15 ±0.03 | 7 ± 0.17 |
| Ti (wt.%) | 0.5 ± 0.4 | 40 ± 0.04 | 33 ± 0.2 |
| Ca (wt.%) | 0.9 ± 0.4 | 0.1 ± 0.04 | 22 ± 0.2 |
| Mg (wt.%) | <LOD | 0.6 ± 0.04 | <LOD |
| P (wt.%) | 0.6± 0.4 | 0.3 ± 0.04 | 0.3± 0.2 |
| Zn (wt.%) | <LOD | <LOD | 0.1 ± 0.2 |
| Fe (wt.%) | 0.3± 0.4 | 0.2 ± 0.04 | 0.1 ± 0.2 |
| Moisture (wt.%) | 2± 0.5 | 46 ± 0.03 | 52 ± 1.2 |
| Ash (wt.%) | 9± 0.4 | 45 ± 0.04 | 57 ± 0.2 |
| Compounds | Cm (µg mL−1) |
|---|---|
| D-Limonene | 15 |
| β-Pinene | 2.5 |
| 1-Octanol | 32 |
| 1R-α-Pinene | 1 |
| P-Mentha-1,5-Dien-8-Ol | 5 |
| 1-Decanol | 37 |
| 2,6-Dimethyl-2,6-Octadiene-1,8-Diol | 4 |
| 1-Dodecanol | 462 |
| 1 Hexadecanol/1-Tetradecanol | 143 |
| Decanol | 44 |
Disclaimer/Publisher’s Note: The statements, opinions and data contained in all publications are solely those of the individual author(s) and contributor(s) and not of MDPI and/or the editor(s). MDPI and/or the editor(s) disclaim responsibility for any injury to people or property resulting from any ideas, methods, instructions or products referred to in the content. |
© 2024 by the authors. Licensee MDPI, Basel, Switzerland. This article is an open access article distributed under the terms and conditions of the Creative Commons Attribution (CC BY) license (https://creativecommons.org/licenses/by/4.0/).
Share and Cite
Zine Filali, N.; Braish, T.; Locoge, N.; Andres, Y. Impact of the Aging Process on the Ability of Decorative Materials Containing Biocides to Support Fungal Growth. Buildings 2024, 14, 3859. https://doi.org/10.3390/buildings14123859
Zine Filali N, Braish T, Locoge N, Andres Y. Impact of the Aging Process on the Ability of Decorative Materials Containing Biocides to Support Fungal Growth. Buildings. 2024; 14(12):3859. https://doi.org/10.3390/buildings14123859
Chicago/Turabian StyleZine Filali, Nouha, Tamara Braish, Nadine Locoge, and Yves Andres. 2024. "Impact of the Aging Process on the Ability of Decorative Materials Containing Biocides to Support Fungal Growth" Buildings 14, no. 12: 3859. https://doi.org/10.3390/buildings14123859
APA StyleZine Filali, N., Braish, T., Locoge, N., & Andres, Y. (2024). Impact of the Aging Process on the Ability of Decorative Materials Containing Biocides to Support Fungal Growth. Buildings, 14(12), 3859. https://doi.org/10.3390/buildings14123859

